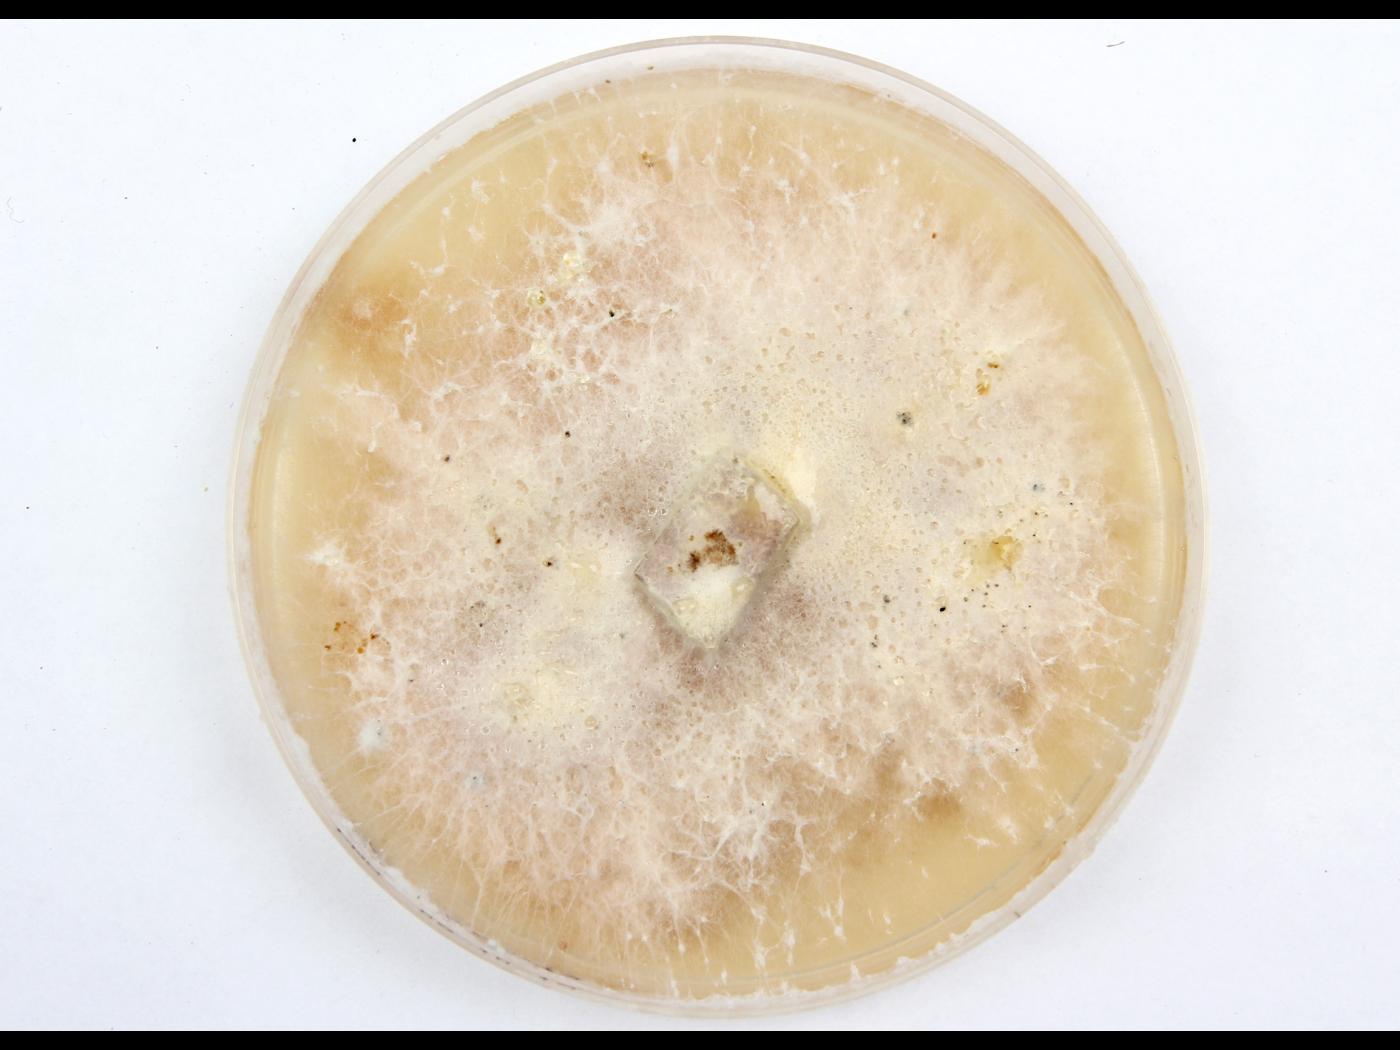

Les espèces appartenant au complexe Fusarium solani sont reconnues comme des agents pathogènes affectant les plantes, les animaux et même l’humain. Toutefois, la taxonomie de cet important groupe fongique demeure complexe et ambiguë, plusieurs espèces et lignées n’ayant été caractérisées que récemment. Les membres du complexe présentent collectivement une large diversité d’hôtes et ont été autrefois classés en formae speciales. Cependant, une analyse phylogénétique récente a montré que ces formae speciales (f. sp.) correspondent en réalité à des espèces distinctes sur les plans biologique et phylogénétique. Ils sont à ce jour divisés en trois principaux clades, le clade 1 et 2 incluant exclusivement des champignons phytopathogènes.
Culture : Aucun pigment coloré, pigment violet ou pigment brun apparaissant dans le milieu de culture PDA (visible dessous).
Mycélium : Septé.
Macroconidies : Phragmospores à 3-5 septations transversales (généralement 3 septations). Fusiformes-cylindriques et légèrement arquées, côté dorsal et ventral parallèles sur une certaine longueur. Cellule apicale plutôt arrondie. Cellule basale variable (arrondie, en forme de pied ou papillée). Parfois regroupées en sporodochies crème (jamais orange). Dimension : 25-42 x 4-6 µm (si 3 septations).
Microconidies : habituellement aucune septation (amérospores) et plus rarement une septation (didymospores). De forme variable (ovale, ellipsoïde, réniforme (en forme de rein) et fusiforme). Agglomérées ou produites en chaînes. Provenant du mycélium aérien. Dimension : 9-16 x 2-4 µm. Produites par de longues (45-80 µm) monophialides (absence de polyphialide).
Chlamydospores : Seules ou en chaînes de deux. Lisses ou verruqueuses. Terminales ou intercalaires. Dimension : 10-11 x 8-9 μm. Ces structures peuvent survivre dans le sol durant l'hiver.
Les macroconidies de Fusarium solani peuvent parfois être confondues avec des conidies de Cylindrocarpon sp.
Le stade sexué et asexué peuvent être observés en même temps.
Booth C. (1971). The Genus Fusarium. Commonwealth Mycological Institute, Kew, Surrey, England. 237 p.
Coleman, J.J. (2016), Fusarium solani species complex. Molecular Plant Pathology, 17: 146-158. https://doi.org/10.1111/mpp.12289
Leslie J.F. & Summerell B.A. (2006). The Fusarium Laboratory Manual. Blackwell Publishing. 388 p.
Nelson P.E., Toussoun T.A. & Marasas W.F.O. (1983). FUSARIUM SPECIES - An Illustrated Manual for Identification. The Pennsylvania State University Press. 193 p.
Noms des maladies des plantes au Canada - 4e édition (2003). Société de protection des plantes du Québec (SPPQ). 340 p.
NCBI : Taxa descriptions (Fusarium solani)
http://coproweb.free.fr/mycoweb/texte/76.htm